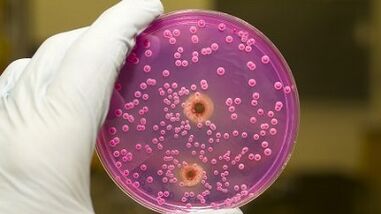
Pathological discharge in men when excited

The discharge of the urethra that men notice during sexual arousal is a normal physiological phenomenon.It is provided by nature itself to moisturize the mucous membrane of the genital organ.However, it is important to pay attention to the color of discharge during an erection.If they are transparent, this is considered an indicator of health.In the case of a change in color and consistency and occurrence of pain, it is necessary to talk about pathological changes and the presence of infections.
The state of health of the genitourinary system can be judged by external signs of discharge.The initial change in its characteristics determines the degree of pathological processes that occur in the body.All signs of a man can be determined independently and, over time, seek medical help.
General characteristic
The discharge in men is different and depends on individual characteristics.Someone is abundant and occurs regularly for others, they are scarce or not noticed.Anyway, if a man is healthy, a transparent liquid is released when excited by the penis, which is absolutely normal and not a sign of deviations.
The medical name of secretion secreted during an erection is urethrome.A liquid that appears in the urethral canal before intercourse or immediately before ejaculation is called pre -enacted.This mucus plays the necessary function - neutralizes the acidic environment in the vagina, addicted to sperm.Thus, the necessary environment for egg fertilization is prepared.
Pre -ejaculation contains active sperm and, even after surface penetration, egg fertilization may occur.

The release of the secretory liquid occurs not only before sexual intercourse, but also in the morning, which is associated with an increase in testosterone level - male sex hormone.Spontaneous ejaculation, or pollution, occurs most often in adolescents during growth and men who haven't had sex for a long time.
Less transparent discharge in men comes out when intestinal emptying.This phenomenon is called the defecation prostate and occurs due to the strong tension of the abdominal muscles.
Natural generations for the body:
- Smegma- The product of the sebaceous glands is constantly produced, located under the foreskin skin.During hygiene procedures, it is released, otherwise its excessive accumulation becomes a favorable environment for the development of pathogenic microflora, which causes inflammatory processes;
- sperm- It consists of sperm produced by the sex glands.It begins to stand out during ejaculation during sexual discharge.White, viscous and thick ejacular.Lack of ejaculation during sexual intercourse or, conversely, spontaneous seed expiration without any effect indicates diseases of genitourinary organs.
Pathological discharge
The male reproductive system is a complex mechanism, an important part of which is the discharge during erection, divided by two types: physiological and pathological.If the former are considered the norm and, at the same time, the patient does not need medical intervention, the latter requires a lot of urgent attention and measures to avoid irreversible consequences.
Pathological isolations are infectious and non -infectious.The first is divided into specific ones that are caused by sexually transmitted and non -specific diseases that occur when exposed to harmful microorganisms and bacteria.This includes chlamydia, ureaplasmic candidiasis, herpes and others.
Non -infectious reasons include allergies, lesions of the mucous membrane of the urethral canal, as well as narrowing of ureter as a result of the effects of chemicals.
This urethral discharge appears constantly often and differs in the following signs:
- Volume - Much or drops;
- External manifestations The color varies from a whitish shadow to dirty or greenish yellow;Instead of transparency, they are muddy;
- Impurities - Blood veins, purulent interleaved, mucus clots;
- Consistency - liquefied or, inversely, very thick;
- The smell is a painty or unpleasant sour.
Depending on the state of the male immune system, existing and infectious pathogen types, discharge will be different, which helps determine its nature.
White discharge
The main reason for the appearance of white discharge in men is the candidate urethritis, which is inherent in the following symptoms:
- sour, remnant of the smell of yeast emanating from the urethra;
- White consistency covers that covers the head of the penis;
- Pain in the groin and trunk of the penis, accompanied by itching;
- discharge during urination;
- irritation in the form of red spots;
- Rubber with sex.
The designated discharge can be observed with mycoplasmosis, ureaplasmosis and chronic prostatitis, which are characterized by false desire to the bathroom, incomplete emptying, accompanied by burning, a decrease in libido and power.
Advanced inflammation in the prostate is more often the cause not only of sexual disorders, but also the inability to have children.
Purulent discharge
They consist of mucus, dead particles of epithelium and leukocytes, are characterized by a yellow or yellow green hue, which indicates the presence of diseases:
- gonorrhea- inherent in viscous and dirty discharge, nonstop during the day, burning in the urethra after urination;
- Trichomoniasis- In the early stage, it continues without significant symptoms, except for the appearance of yellow discharge.As the infection develops, the gnoid mucus causes inflammation in the genitals.
A characteristic smell
The unpleasant smell of discharge during an erection is explained by an infection that impressed the genitourinary organs.Do not exclude the neglect of hygienic procedures.Sumegma, accumulated, becomes a favorable environment for harmful bacteria.Its rapid reproduction leads to inflammation of the man and male organ head under the brake, causing a poignant smell.
The same manifestations are observed in men suffering from diabetes and metabolic disorders.
Bloody discharge
Blood traces in the seed, which is released in the form of red threads, is a sign of infectious damage to the pelvic organs.The discharge volume depends on the duration of the disease.During the long period, the mucous layer is destroyed, exposing small capillaries, which, under the smallest effect, begin to bleed.
There are also other reasons:
- Medical procedures- Taking a stain from the urethra, installation or removal of the catheter;
- sand or kidney stones- When they pass through the urethra, it is damaged, the blood is mixed in the urine;
- Oncopathology- Blood interllations are manifested with testicles, testicles and prostate gland cancer.
According to external discharge signs, a diagnosis cannot be accurately.In case of suspicion of the pathology, you need to undergo an exam, after which, based on the results, the specialist will prescribe the necessary treatment.Then it will be possible to maintain male health and avoid irreversible consequences.
































